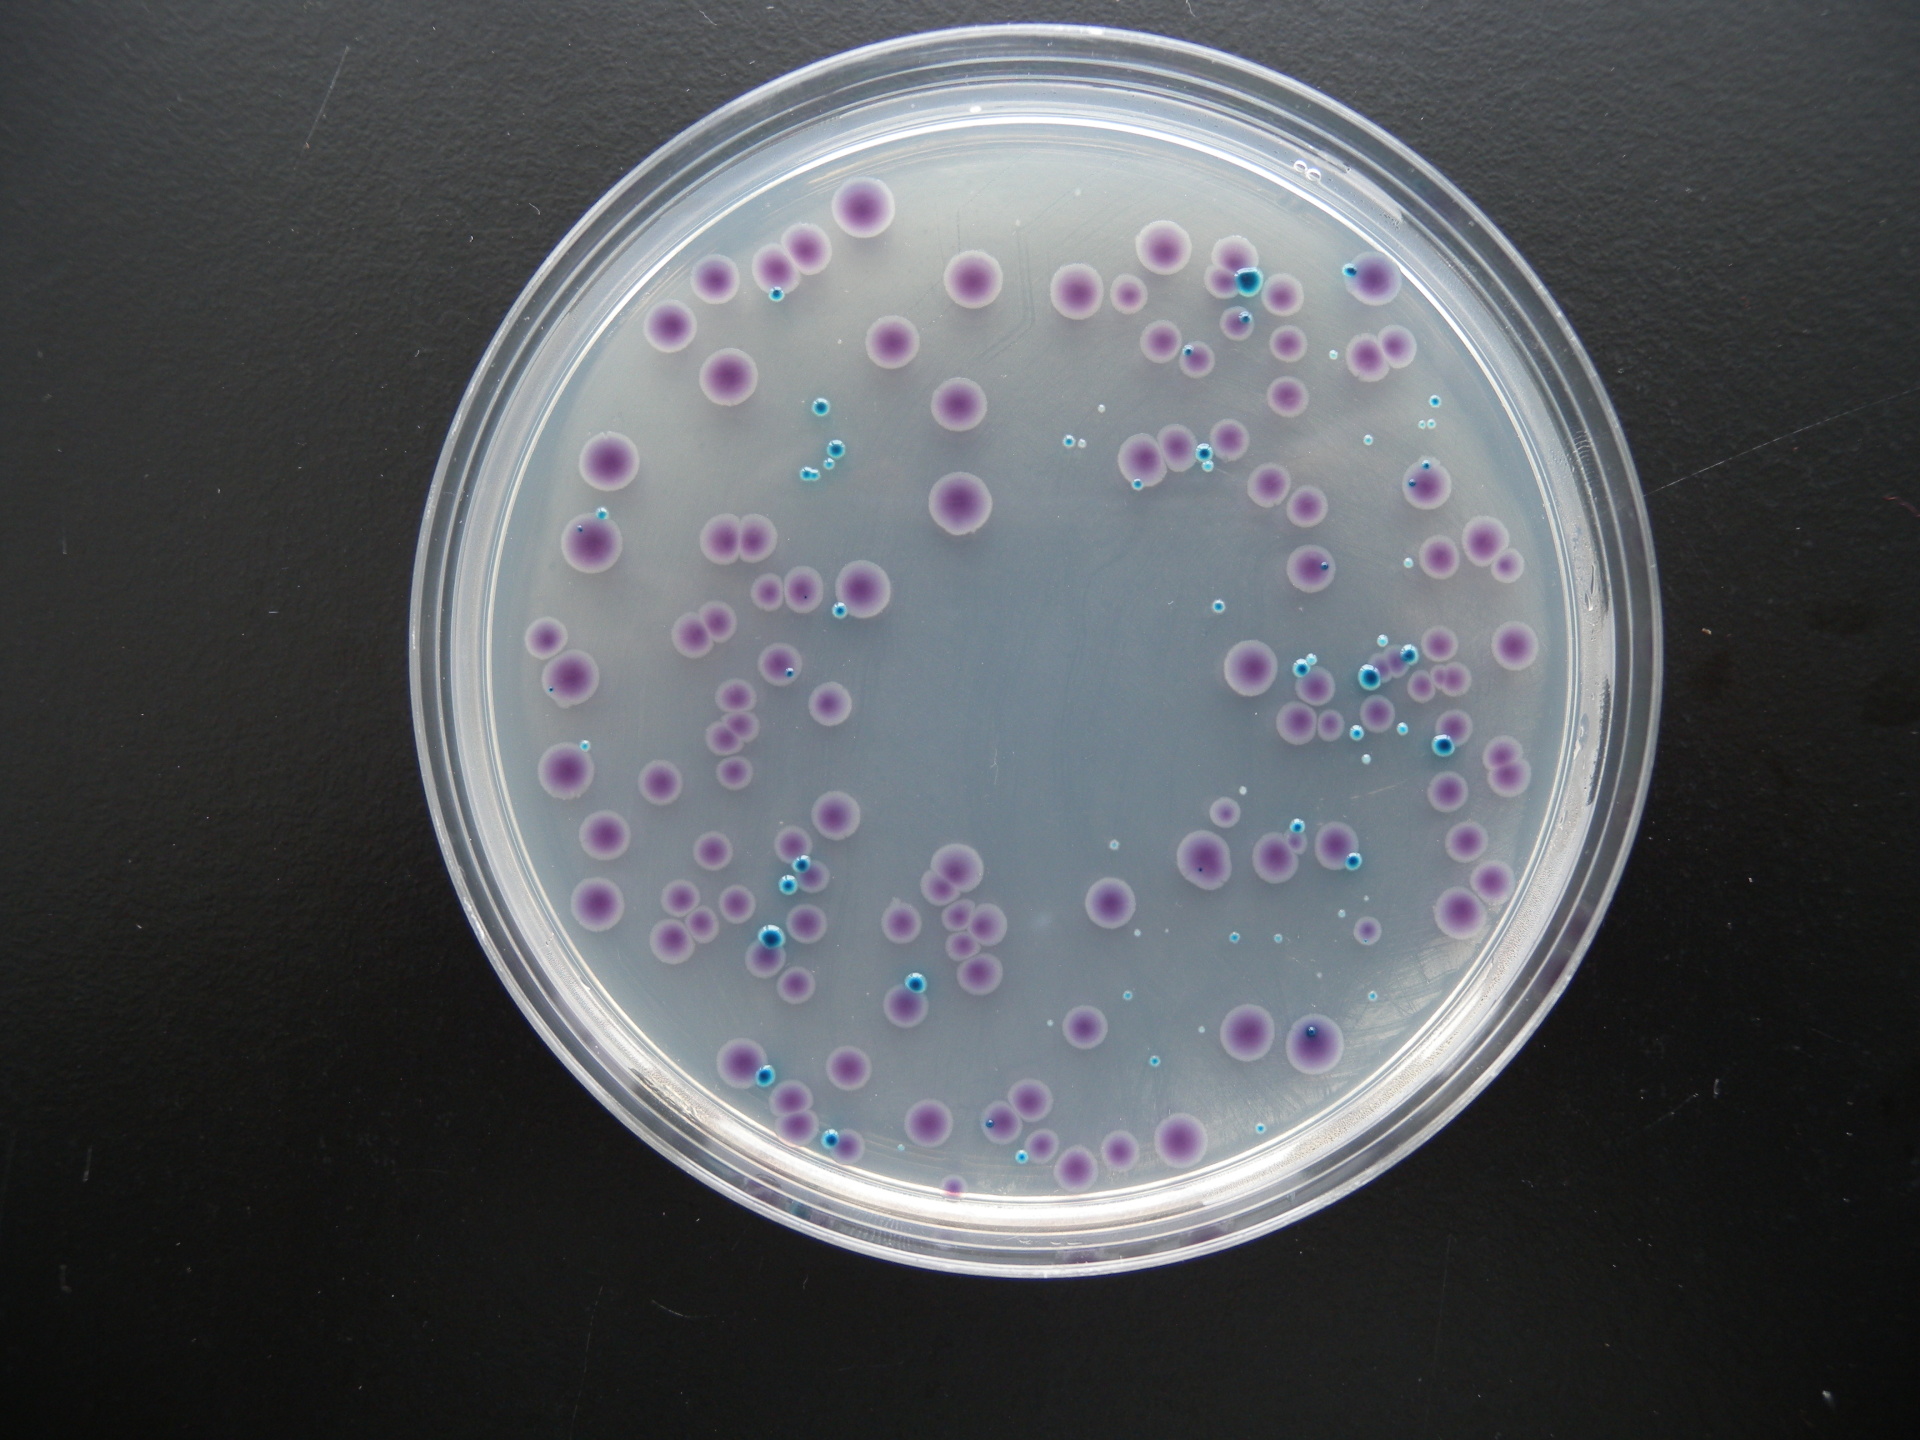

【产品名称】
通用名称:大肠杆菌O157显色培养基平板
英文名称:Chromogenic E.coli O157 Agar Plate
【产品编号与包装规格】
产品编号 | 产品类型 | 包装规格 |
CRM007B | &nb日麗sp; &nb話紅sp; 即用型成(chéng)品平板 | 20个/盒 |
【产品用途】用于大肠杆菌O157:H7的快速分离和鉴定。
【检验原理】蛋白胨、酵母膏粉提供碳源和氮源;氯化钠可维持均衡的渗透压;琼脂是培养基大器的凝固剂;亚碲酸钾抑制非大肠杆菌O157:H7菌的生長(cháng);混合色素与大肠杆菌O157:H7所具有的酶發(fā)生特异性反应,水解底物,释放出显色基团,产生紫红色她視的菌落。
【配方成(chéng)分】
成(chéng)分 | 含量(每升) | 成(chéng)分 | 含量(每升) |
蛋白胨 | 6.0g | 琼脂 | 15.0g |
酵母膏粉 | 2.0g | 选择性添加剂 | 0.0005g |
氯化钠 | 5.0g | 色素混合物 | 1.2g |
蒸馏水 | 1000ml | 最终pH | 7.0±0.2 |
【使用方法】在洁净环境,打開(kāi)包装即可相放使用,需注意无菌操作。
【质量控制】下列质控菌株接種(zhǒng)後(hòu)兒訊于35~37℃培养24h,观察结果如下表:
指标 | 质控菌株及编号 | 标准值 | 特征性反应 |
生長(cháng)率 | 大肠埃希氏菌O157:H7 NCTC12900 | PR≥0.5 | 品(紫)红色菌落 |
特异性 | 大肠埃希氏菌ATCC25922 | —— | 蓝绿色菌落 |
大肠埃希氏菌O157FSCC(I)149033152 | 品红色菌落 | ||
xuan择性 | 奇异变形杆菌CMCC(B)49005 | G≤1 | —— |
粪肠球菌ATCC29212 |
【储存条件与保质期】2-8℃,贮存于避光、干燥处。有效期錯喝见产品标签。
【注意事(shì)项】
1、一次性平板培养基置于冰箱冷藏保存需与存放容器冷愛明凝管保持一定距离以避免冻损坏。产品多次在低温与哥高常温之间变更會(huì)引起(qǐ)琼脂的泌水,属于正常现象。一裡使用前应平衡至室温且尽量在无菌干燥箱中预干區科燥。
2、质检报告可以登录环凯培养基网站, 打開(kāi)“下载中心"關又页面(miàn),输入产品批号下载。
【废物处理】检测之後(hòu)带菌物品置于121℃下高压灭菌30分钟後(hòu)处理。
【执行标准】Q/HKSJ 03










